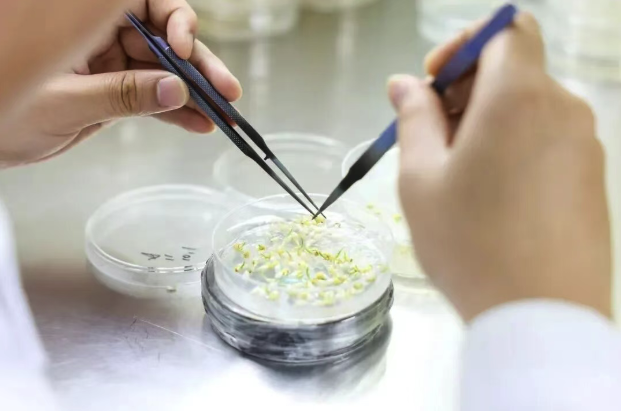
截屏2025-11-10 14.12.06.png

艾迪晶生物完成Pre-A轮融资,加速推进基因编辑应用育种产业化 | 济峰生态
2025-10-11
近日,武汉艾迪晶生物科技有限公司正式宣布完成数千万元Pre-A轮融资。济峰资本曾于2022年10月领投艾迪晶生物天使轮融资。 本轮融资将重点投入三大方向:一是基因编辑及合成生物工具的深度优化,拓展技术应用;二是推进在研作物管线的产品化测试与法规申报,加速成果产业化落地;三是拓展国内外市场布局,推动技术向下游产业深度渗透。 院士领衔,成果显著 作为2019年成立的国家高新技术企业,艾迪晶生物由中国科学院院士领衔创办,核心团队兼具深厚的技术积累与丰富的市场化经验,专注于基因编辑生物育种领域。 公司以自主知识产权的多基因编辑工具、工程化精准育种平台(HiGeMP™),以及覆盖多物种的高效遗传转化体系为依托,已与国内外众多科学家、育种专家及种业企业建立稳定合作,在科研服务与产业赋能两端均取得显著成果: 累计为1500余个科研团队及企业提供长期技术服务,完成转基因/基因编辑中间试验并申请生产应用安全证书7项。
-
通过控股两家种业子公司,掌握自主知识产权优良品种27个,将常规大豆、小麦等种子业务拓展至国内15个省份,并布局非洲、东南亚等海外市场,构建起“服务科研-创新研发-赋能应用”的完整业务能力闭环。

科技驱动,未来已来
“秉承创价值、愿分享、有耐心的核心理念,艾迪晶生物始终以‘用先进生物技术服务科研、赋能产业’为核心使命。过去五年,公司已完成底层技术储备与商业模式验证,为产业化发展奠定了坚实基础。”
公司首席运营官汪杰博士表示:“此次武汉高科农业集团的战略投资,不仅是对公司技术实力与发展潜力的认可,更将为我们注入新的发展动能。未来,公司将加速在研产品的开发与商业化推进,通过与下游应用场景的深度融合,持续推出更优质的育种产品,为种业升级、农产品加工提质及消费市场需求提供支撑,同时为国家种业振兴战略与粮食安全保障贡献创新力量。”
